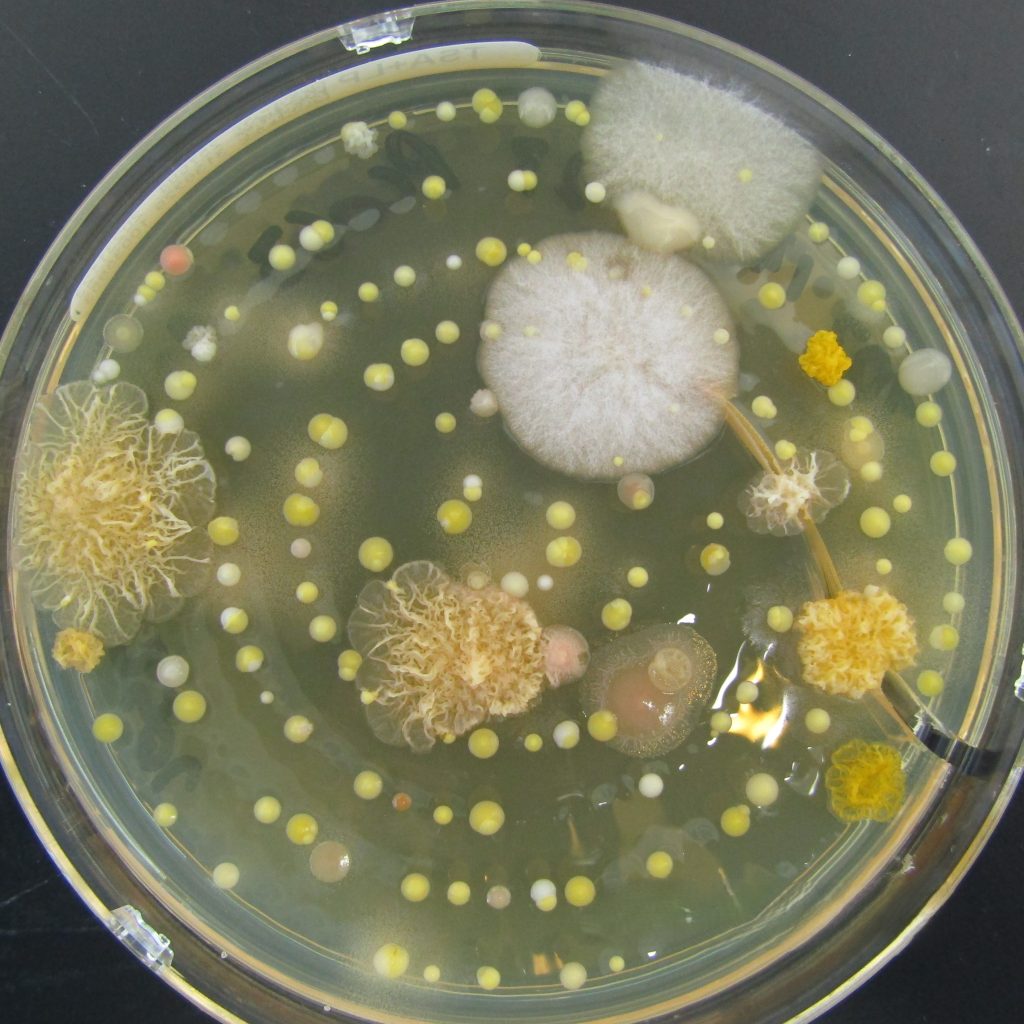

OOS investigation and remediation
With extensive experience in microbial investigations, we offer a thorough and expert analysis of contamination issues within cleanrooms and water systems. By working closely with your manufacturing, engineering and QA teams, we aim to identify root causes and implement corrective actions that are both effective and cost-efficient. Whether you are addressing a particularly challenging contamination investigation and require an external perspective to collaborate with your Quality Control team, or are experiencing a temporary resource shortage, we are available to provide support.

Contamination control risk assessments (CCS)
We have extensive experience in contamination control risk assessments, collaborating closely with cross-functional teams to pinpoint high-risk processes and recommend robust control measures tailored to specific operational needs. Whether you’re establishing a new facility or process, with or without a CCS strategy, we will help you meet regulatory expectations.
Training
Training is a cornerstone of our offerings, with customised workshops designed to empower your team in contamination control, cleanroom practices, and basic microbiology. These programmes are designed to bridge knowledge gaps, enhance team competency, and promote a culture of quality excellence. We take great pleasure in introducing the field of microbiology to non-microbiologists. Whether your environmental monitoring plates are reviewed by QC staff who are not specialists in microbiology, or your manufacturing and engineering teams require a fundamental understanding of contamination control, we are eager to support you.


Cleanroom environmental monitoring setup
We offer consultancy in cleanroom environmental monitoring setup and qualification, a pivotal step in ensuring your facility adheres to industry standards. Through environmental monitoring plans and robust risk assessments, we help organisations maintain high levels of sterility assurance and confidence that their monitoring programme will meet regulators expectations.
Auditing
Auditing is a vital part of ensuring compliance and operational excellence in Quality Control laboratories. With our in-depth experience in GXP compliance, we offer comprehensive audits tailored specifically for QC settings. Our approach involves a meticulous review of protocols, practices, and documentation to uncover areas for improvement and to mitigate potential regulatory risks. We work collaboratively with your team to ensure that the recommendations are both practical and effective, enhancing your laboratory’s ability to meet and exceed industry expectations. If you are looking to strengthen your compliance profile and fortify your operations against regulatory scrutiny, we are here to provide expert guidance and actionable solutions.

